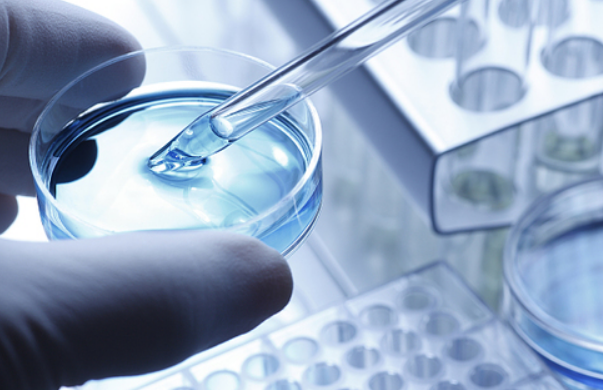
『天狼星』新冠“克星”就快来了！中国专家公布重大成果，结束的那一天快了

『天狼星』新冠“克星”就快来了!中国专家公布重大成果,结束的那一天快了

文章图片

文章图片
从国家卫计委的最新通报当中 , 我们可以知道 , 在5月18号的全天当中 , 中国新增了新冠病毒确诊病例6例 , 其中三例来自于境外输出 , 吉林新增两例本土病例 , 没有新的死亡病例 。 从这个最新的数据当中我们可以知道 , 我国在新冠病毒疫苗当中所采取的很多措施已经见到成效 。 但是不断新增加的人数也给我们敲响了警钟 , 科学家们只有早日研究出新冠病毒方面的疫苗 , 大家的安全才可以得到保障 。 近期我国又传来两个好消息 , 新冠“克星”就快来了!中国专家宣布重大成果 , 结束的那一天快了 。
自从新冠爆发之后 , 我国各个专家团队立马开始对其进行研究 , 除了弄清楚新冠的来源以及本质之外 , 还要研制出疫苗 。 秦川团队、张云俊团队就是其中的一员 , 如今他们已经取得了重大成果 。 根据他们发表在知名杂志《科学》上论文表示 , 新冠疫苗在动物身上试验已经取得了非常好的效果 。 【『天狼星』新冠“克星”就快来了!中国专家公布重大成果,结束的那一天快了】
根据最新的成果可以知道 , 这篇研究当中所提到的在在动物身上用所研发的新冠病毒疫苗所取得的效果真的很不错 。 在实验开始的时候 , 最佳先从11名感染新冠病毒的住院患者当中提取了很多个病毒植株 , 5个来自于中国 , 3个来自于意大利 , 1个来自于瑞士 , 1个来自于英国 , 1个来自于西班牙 。 我们都知道病毒在不同的人种、环境下是会发生变异的 , 所以这次试验采取了11个毒株 , 几乎覆盖了全世界 , 在一定程度上已经代表了一种新的流行新冠病毒种类 。
从科学家们把这11个病毒植株移植到恒河猴身上之后可以发现 , 恒河猴在身上出现了类似于新冠病人的表现 。 之后科学家们开始给恒河猴进行疫苗的治疗 , 在经过初步阶段之后可以发现 , 恒河猴病毒数量明显下降 。 在进行治疗的第7天之后 , 科学家们在恒河猴的咽喉、肛门和肺部都没有检测到病毒的痕迹 , 也没有检测到抗体逐渐增多的迹象 。 在经过一段时间的治疗之后都可以发现 , 新冠病毒疫苗在恒河猴的身体上已经体现出很好的效果 , 这意味着新冠“克星”就快来了 。
中国科学家在新冠疫苗研究当中所取得的重要成果 , 让我们感觉到特别欣喜 , 这是不是已经代表新冠病毒疫苗在短时间内就已经能够快速研制?并且也能够在很快的时间内用到临床当中?当然这或许是我们每一个人的愿望 , 但是要想真正的做到这一点 , 还并不是那么容易 。 毕竟每一种疫苗的研发都需要一个很长的过程 , 在疫苗研制成功之后 , 还需要多次进行动物甚至是人体试验 , 才可以知道该款疫苗到底有没有效果 。 所以对于科学家们来说 , 恒河猴新冠病毒疫苗的实验是一种更大的突破 。但是从眼下的情况来看 , 新冠病毒疫苗的研发在全球各国都已经快速展开 , 中国科学家们所取得的重要成果 , 可以代表了一个重要的研究阶段 。 目前在国内已经有三类新冠病毒疫苗获批进入临床实验阶段 , 其中一款腺病毒载体疫苗已经进入2期人体临床实验阶段 。 如果疫苗能够真的上市或者是大批量生产的话 , 这或许就可以改变线下新冠病毒大规模扩散的危险 , 同时也可以让全球的确认人数和死亡人数下降 。 当然想要达到这个阶段 , 对于中国的科学家们来说都是一个巨大的挑战 , 现在不断传来的好消息 , 也是在告诉我们要继续坚持 , 结束的那一天已经快了 。
推荐阅读
- 「冠状病毒」“恐怖”消息再次传来!新冠病毒再次变异!比原版病毒感染力强3倍!
- 腺病毒:成功了!新冠克星终于来了!疫苗开始使用!
- 「三体」“重磅揭秘”!研究发现新冠病毒再次变异,比原版感染能力强3倍!
- 『娜美』神秘又强大,天选的种族——娜美克星人解密
- 数据猿|#榜样的力量#中诚信征信新冠肺炎全国疫情感染场所实时查询平台
- 松鼠热点|美国“买断”对抗新冠关键药物?世卫:正核实相关报道
- 松鼠热点|普通人何时可接种新冠疫苗?中国疾控中心主任表态
- 『腺病毒』新冠克星终于来了!!!疫苗开始使用!!!
- 【科学家】可怕!新冠病毒会使被感染的人体细胞“僵尸化”
- VR笃信者|VR直播的“破”与“立”,虚拟现实技术时代
